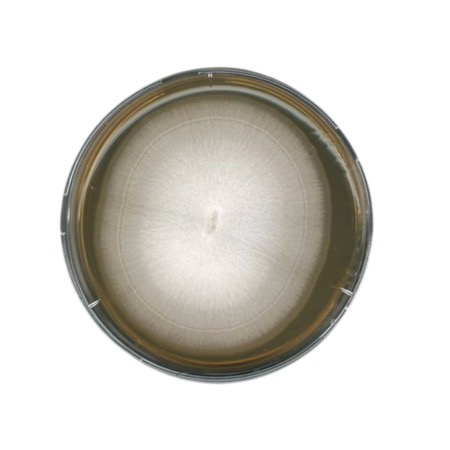

GranuCult® Malt extract agar is a high-quality culture medium formulated to provide optimal growth conditions for a wide range of fungi. The high carbohydrate content (maltose, glucose, sucrose) promotes rapid growth, while the acidic pH suppresses the majority of accompanying bacterial flora. This medium is manufactured in a granulated form to ensure high safety by minimizing dust generation and providing excellent wetting properties for rapid dissolution. It is compliant with ISO 16212, USP, JP, and EP standards.
Advantages
- Granulated form: significantly reduces dust formation and inhalation risk for the user.
- Compliance: strictly follows ISO 16212 and major pharmacopoeias (USP, JP, EP).
- High selectivity: the acidic pH level naturally inhibits bacterial growth.
- Performance: supports robust growth of yeasts and molds for accurate enumeration.
- Ease of use: excellent solubility and homogeneous distribution of components.
Technical specifications
| Catalogue number |
1.05398 |
| Product name |
Malt extract agar GranuCult® prime |
| Brand |
Merck / GranuCult® |
| Compliance |
ISO 16212, USP, JP, EP |
| Typical composition (g/l) |
Malt extract 30.0; Peptone from soymeal 3.0; Agar-agar 15.0 |
| pH value |
5.6 ± 0.2 (H2O, 25 °C, after autoclaving) |
| Solubility |
48 g/l |
| Appearance |
Granular, brown |
| Storage temperature |
15–25 °C |
Available packaging options
| Container Type |
Pack Size |
| Plastic bottle |
500 g |
| Plastic drum |
5 kg |